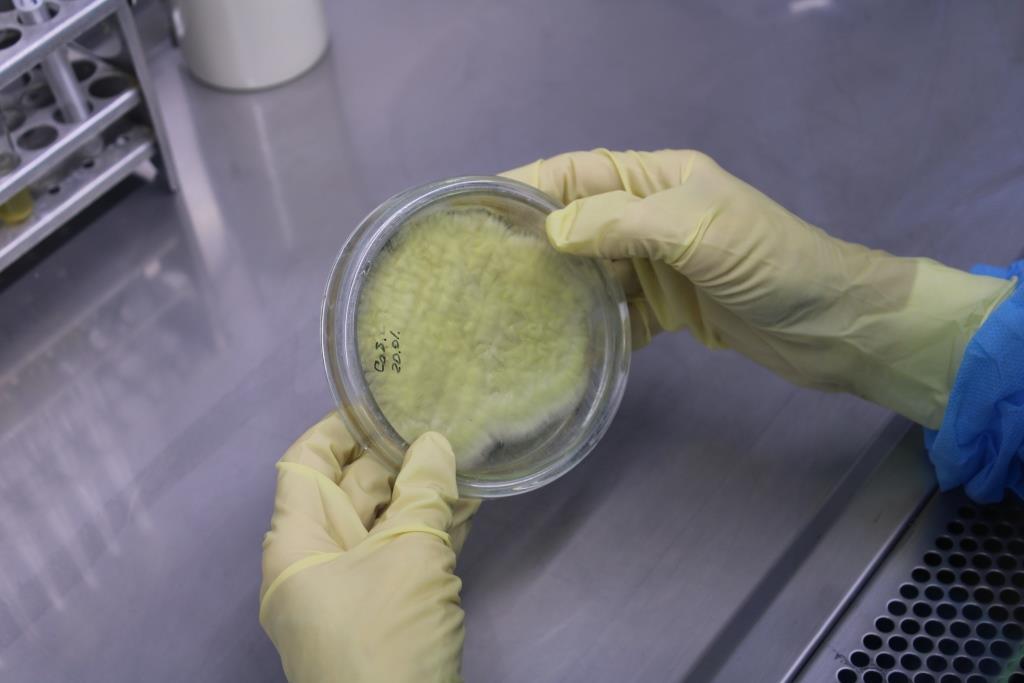

E-mail: panfilkina.elena00@mail.ru
Тел.: 8 (861) 260-87-72

младший научный сотрудник
Околот
Марина Владимировна
E-mail: panfilkina.elena00@mail.ru
Тел.: 8 (861) 260-87-72
лаборант-исследователь
Панфилкина
Елена Викторовна

E-mail: priemnaya@kubzv.ru
Тел.: 8 (861) 260-87-72
лаборант-исследователь
Носуля
Наталья Георгиевна

E-mail: pushkar.2025@internet.ru
Тел.: 8 (861) 260-87-72

младший научный сотрудник
Пушкарь
Елена Сергеевна
E-mail: nastenka.antipova.84@bk.ru
Тел.: 8 (861) 260-87-72
младший научный сотрудник
Антипова
Анастасия Валерьевна

E-mail: Zabashta.anastasia1005@gmail.com
Тел.: 8 (861) 260-87-72
младший научный сотрудник, кандидат биологических наук
Забашта
Анастасия Васильевна

E-mail: vbasankina@mail.ru
Тел.: 8 (861) 260-87-72

старший научный сотрудник, кандидат ветеринарных наук
Басанкина
Виктория Михайловна
заведующий отделом, ведущий научный сотрудник, кандидат ветеринарных наук
Мирошниченко
Петр Васильевич
E-mail: danilchencolesya@gmail.com
Тел.: 8 (861) 260-87-72
старший научный сотрудник, кандидат биологических наук
Данильченко
Олеся Богдановна

E-mail: lisovickaya.ekaterina@mail.ru
Тел.: 8 (861) 260-87-72
старший научный сотрудник, кандидат технических наук
Лисовицкая
Екатерина Петровна

E-mail: mpetvas@mail.ru
Тел.: 8 (861) 260-87-72

• Услуги отдела
• Сотрудники отдела
• Разработки отдела
• Общая информация
Общая информация
Разработки отдела
Перспективные разработки отдела, продукция и услуги:
Мониторинг наиболее распространенных инфекционных заболеваний животных и птиц; разработка комплексной система ветеринарно-санитарной экспертизы, обеспечивающей надежный контроль качества и безопасности продовольственного сырья и продуктов питания животного происхождения; мониторинг контаминации кормов плесневыми грибами и микотоксинами с разработкой лечебно-профилактических мероприятий при сочетанных микотоксикозах животных и птиц.
Ученые отдела эпизоотологии, микологии и ВСЭ обособленного структурного подразделения ФГБНУ «Краснодарский научный центр по зоотехнии и ветеринарии» могут предложить:
1. Проведение диагностики инфекционных заболеваний животных, птиц, рыб и других гидробионтов.
2. Проведение клинико-эпизоотологического обследования животноводческих хозяйств для определения эпизоотической обстановки, клинического статуса животных, птиц и гидробионтов. Установление причин заболеваемости и падежа с последующей разработкой комплекса мероприятий: предупреждение, ликвидация заболеваний и лечебно-профилактические мероприятия.
3. Выделение и типирование микроорганизмов 3-4 групп патогенности, определение чувствительности к фармакологическим препаратам.
4. Разработка рекомендаций по использованию иммунологических препаратов (вакцины, сыворотки, бактериофаги) для профилактики инфекционных заболеваний, а также фармакологических препаратов и средств.
5. Проведение микологических исследований кормов для животных и птиц, рыб с определением токсигенных микроскопических грибов (родов: Mucor, Aspergillus, Fusarium, Candida, Penicillium, Rhizopus и др.).
6. Проведение токсикологических исследований корма (с постановкой биологической пробы на лабораторных животных и простейших).
7. Проведение микотоксикологических исследований кормов (методом ИФА) с определением содержания и концентрации микотоксинов.
Основными направлениями работы отдела эпизоотологии, микологии и ВСЭ обособленного структурного подразделения ФГБНУ «Краснодарский научный центр по зоотехнии и ветеринарии» являются:
- мониторинг инфекционных заболеваний животных, птиц, рыб и других гидробионтов;
- разработка комплексной системы лечения и профилактики заболеваний смешанной этиологии (микозы, микотоксикозы, болезни бактериальной, вирусной и паразитарной этиологии), обеспечивающей надежный контроль качества и безопасности продовольственного сырья и продуктов питания животного происхождения;
- мониторинг контаминации кормов плесневыми грибами и микотоксинами с разработкой комплекса лечебно-профилактических мероприятий при сочетанных микотоксикозах животных и птиц.
На разработки отдела получены более 10 патентов на изобретения и полезные модели, 4 монографии 2 учебных пособия,10 методических рекомендаций.
За последние пять лет выпущено более 200 научных публикаций. Сотрудники отдела принимают активное участие в международных и региональных научно-практических конференциях, семинарах, форумах и выставках, занимаются преподавательской деятельностью. Кроме плановых исследований по гостематике в лаборатории ведется большая дополнительная работа по хоздоговорной тематике, по оздоровлению животных от различных заболеваний.
Из общего перечня научных публикаций института за последние 10 лет сотрудниками отдела издано 3 монографии, учебное пособие под грифом УМО, опубликовано 456 научных статей, зарегистрировано 10 патентов.
Отдел является соисполнителем Гранта РНФ № 24-64-00017 «Бактерии-хищники и нетрансдуцирующие бактериофаги Т4-типа, перспективные для разработки лечебно-профилактических препаратов против Escherichia coli – инфекций цыплят-бройлеров: изучение литической активности in vivo и in vitro, организации геномов и особенностей взаимодействия с кишечной микрофлорой».
В структуру отдела входит микробиологическая лаборатория, предполагающая работу с ПБА III – IV групп патогенности. Данная лаборатория оснащена микробиологическим ламинарным боксом второго класса (BA-safe, компании ОДО Белаквилон), термостатами медицинскими, водяной баней серии TW-2, центрифугой медицинской серии СМ-50, шейкер-инкубатором 50 л US-3020, инкубатором-встряхивателем для планшетов и стрипов версии Stat Fax 2200, фотометром лабораторным медицинским Stat Fax 2100 и стерилизаторами паровыми – автоклав ВК-75-01.
Разработаны и внедрены в практику концентрированная вакцина против лептоспироза и инактивированная поливалентная вакцина против болезней свиней (авт.свидетельство № 1439784) с содержанием антигенов: парвовирусной инфекции, лептоспироза, болезни Ауески и хламидиоза. Данная вакцина выпускается биофабриками страны до настоящего времени.
Сотрудниками отдела проводится активная работа по разработке новых препаратов (авторские свидетельства № 1238290, № 1584181) по разработке способов лечения различных заболеваний животных патенты № 218802, № 2188650, № 2327472).
В числе разработанных на основе профильных тем препараты аверсект-2, иверсект, универм (порошок), альвет-суспензия. В последние годы разработаны препараты гидропетон-плюс (инъекционная форма) и абиопептид-плюс (оральная форма). Разработаны и опробировапны лекарственные средства карцесел и карвит, включающие комбинации доступных веществ: бета-каротин, витамины С и Е, диацетофенонилселенид.
Разработан адсорбент Силимикс, обладающий свойствами адсорбции, ионообменника и катализатора способствует элиминации и снижению в продуктах животноводства микотоксинов, тяжелых металлов, радионуклидов и других ксенобиотиков. Разработана комплексная система лечебно-профилактических мероприятий при сочетанных микотоксикозах крупного рогатого скота. Изданы рекомендации по «Комплексной системе диагностики и профилактики микотоксикозов у животных», «Комплексная система диагностики, профилактики и терапии сочетанных микотоксикозов кур», «Диагностика и профилактика микотоксикозов животных и птиц в краснодарском крае», «Комплексная система лечебно-профилактических мероприятий при сочетанных микотоксикозах крупного рогатого скота».
Сотрудники отдела дважды получали серебряные и один раз бронзовые медали Всероссийской сельскохозяйственной выставки "Золотая Осень".
Отдел эпизоотологии, микологии и ветеринарно-санитарной экспертизы
Определение и оценка токсичности на простейших (стилонихии)

Работа с микроорганизмами в ламинарном боксе

Культивирование бактериофагов в шейкер-инкубаторе
Оценка роста микроскопических грибов на специфической среде Сабуро
Пробоподготовка клинического материала


Проведение планерки отдела



Паразитологическое исследование фекалий животных
Микроскопия плесневых грибов и токсикологический анализ по определению микотоксинов на приборе ИФА








